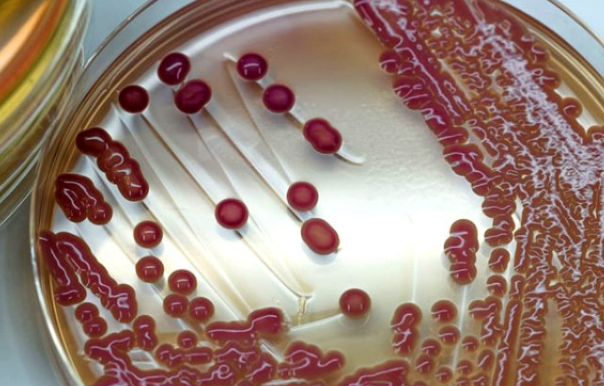

Belçika'da yaşayan ve adı açıklanmayan 47 yaşındaki bir adam, alkol almadığı halde gün boyunca aralıklı olarak kendini sarhoş hissettiğini fak etti ve tıbbi yardım almaya karar verdi.
Öte yandan bu nadir sendrom son 30 yılda sadece 5 kez görüldü. Geçtiğimiz Eylül ayında Çin'de bir hastanın aynı durumdan muzdarip olduğu anlaşıldı. Bu kez ise hastanın bağırsağında yoğun miktarda Klebsiella pneumoniae mikrobu bulundu.
Doktorlar, adamda vücudun şeker ve karbonhidratları alkole dönüştürmesine neden olan nadir bir durum olduğunu söylediler. Auto – Brewery sendromu olarak adlandırılan bu durum son derece nadir görülüyor. Bu duruma bağırsak florasındaki bir maya bakterisi neden oluyor.
Doktorlar da adama bu durum için tipik olarak etkili olan mantar önleyici ilaçlar reçete ettiler ve düşük karbonhidratlı bir diyet uygulamasını söylediler. Ancak bu ilaçlar işe yaramadı, hatta durumu daha da kötüleşti.
47 yaşındaki adamın durumu o kadar kötüleşti ki karısı nefesinden alkol kokusu alabiliyordu. Dört haftalık ilaç tedavisinin ardından adamın kanındaki alkol miktarı alkol kullanmamasına rağmen oldukça fazlaydı. Hatta bu nedenle ehliyeti elinden alındı, çünkü polis alkollü araç kullandığını düşündü.
47 yaşındaki adam, bir gün araba kullanırken polis tarafından kenara çekildi ve polis onun sarhoş olarak araba kullandığını düşündü. Çünkü alkol testinde kanındaki alkol miktarı fazla çıkmıştı. Yüksek promil alkolle araç kullandığı için ehliyeti elinden alındı.
Doktorlar ise ona daha zorlu bir tedavi önerdi; Fekal mikrobiyota nakli, daha anlaşılır deyişiyle dışkı nakli. Bu operasyonda doktorlar dışkıda bulunan bakteri olan dışkı mikrobiyotasını hastanın ince bağırsağına aktarıyorlardı. 47 yaşındaki adam bu nakli kabul etti. Böylece adamın 22 yaşındaki kızının dışkısı alındı ve adama nakledildi. Hayatı normale dönen adam ehliyetini de geri aldı. Şimdi kendi istediği zaman alkol tüketip sarhoş olabiliyor. En önemlisi ise tam olarak 34 aydır böyle bir dur
Bu nakil operasyonu Annals of Internal Medicine'da yayınlanan bir makalede kendine yer buldu. Makalenin yazarı doktorlar gut fermantasyonu sendromunda standart tedavilere direnç gösterilmesi durumunda bu yöntemin uygulanabileceğini belirtti.